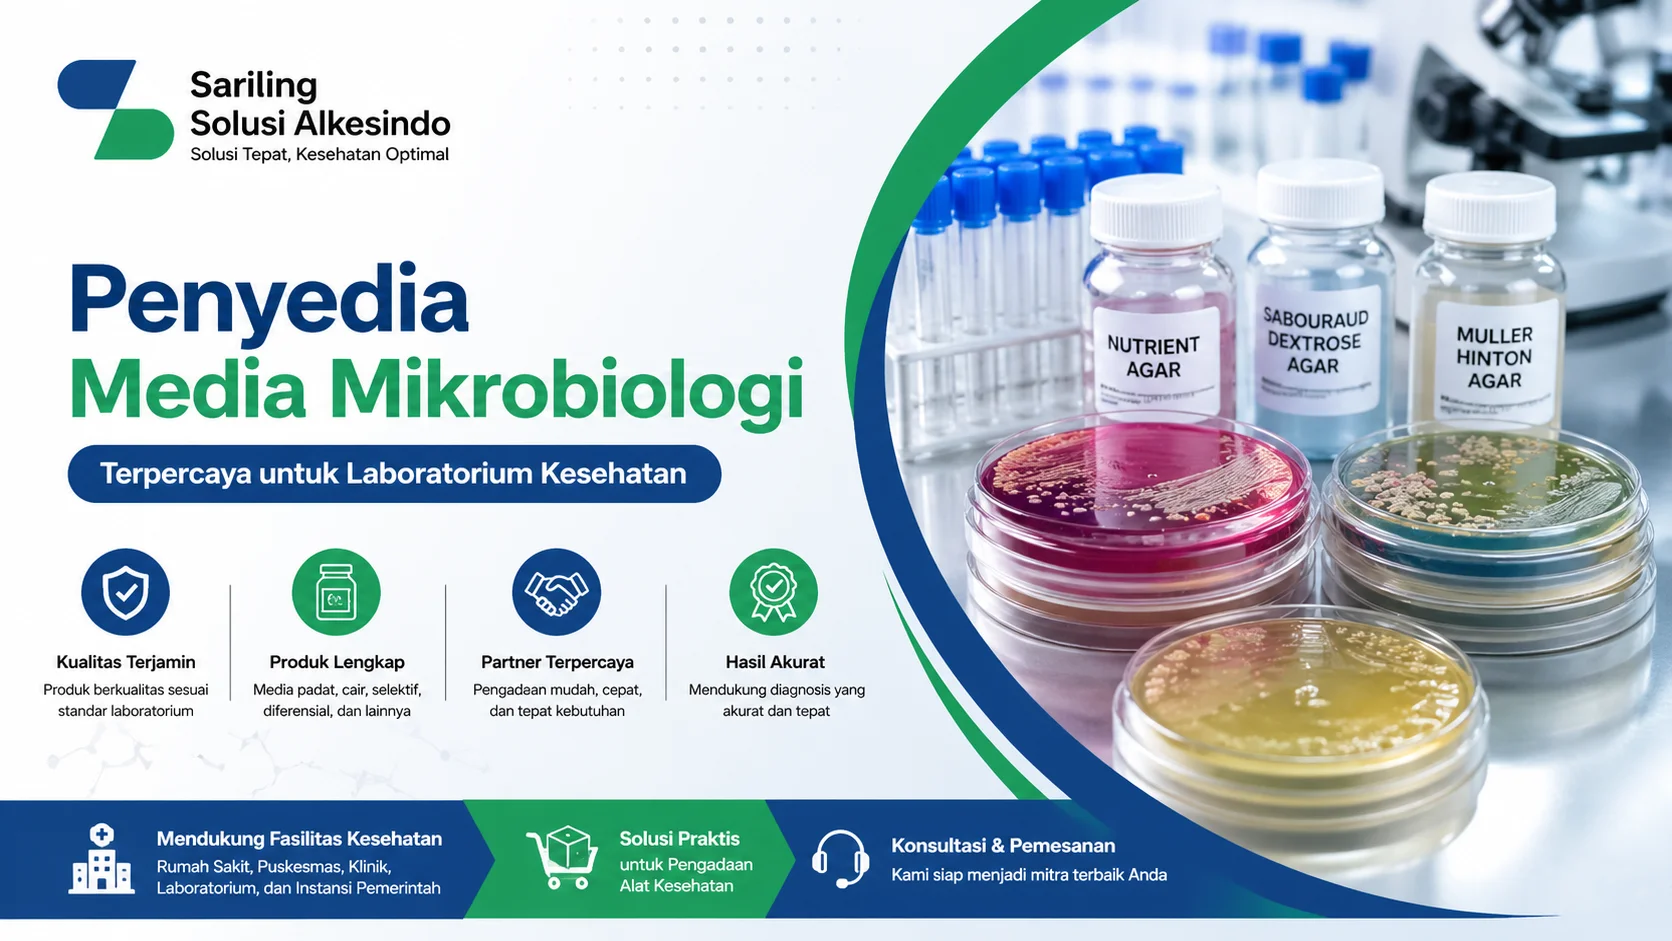
Penyedia media mikrobiologi laboratorium dengan ilustrasi petri dish dan peralatan lab serta logo Sariling Solusi Alkesindo
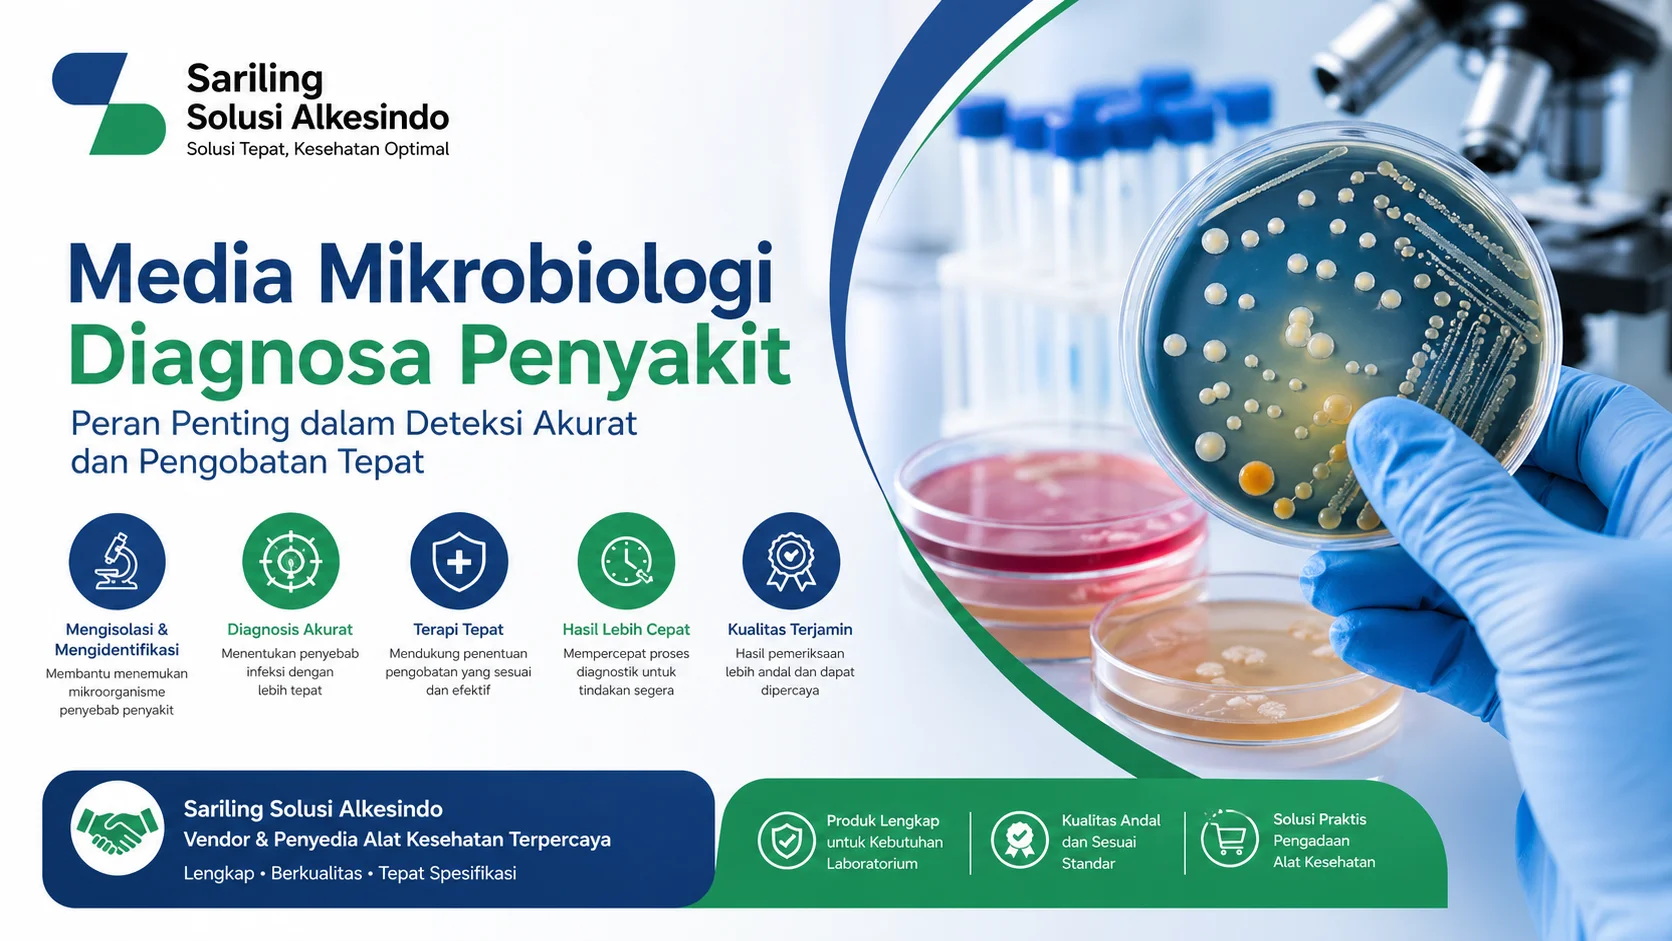
Media mikrobiologi diagnosa penyakit dengan ilustrasi petri dish di laboratorium dan logo Sariling Solusi Alkesindo
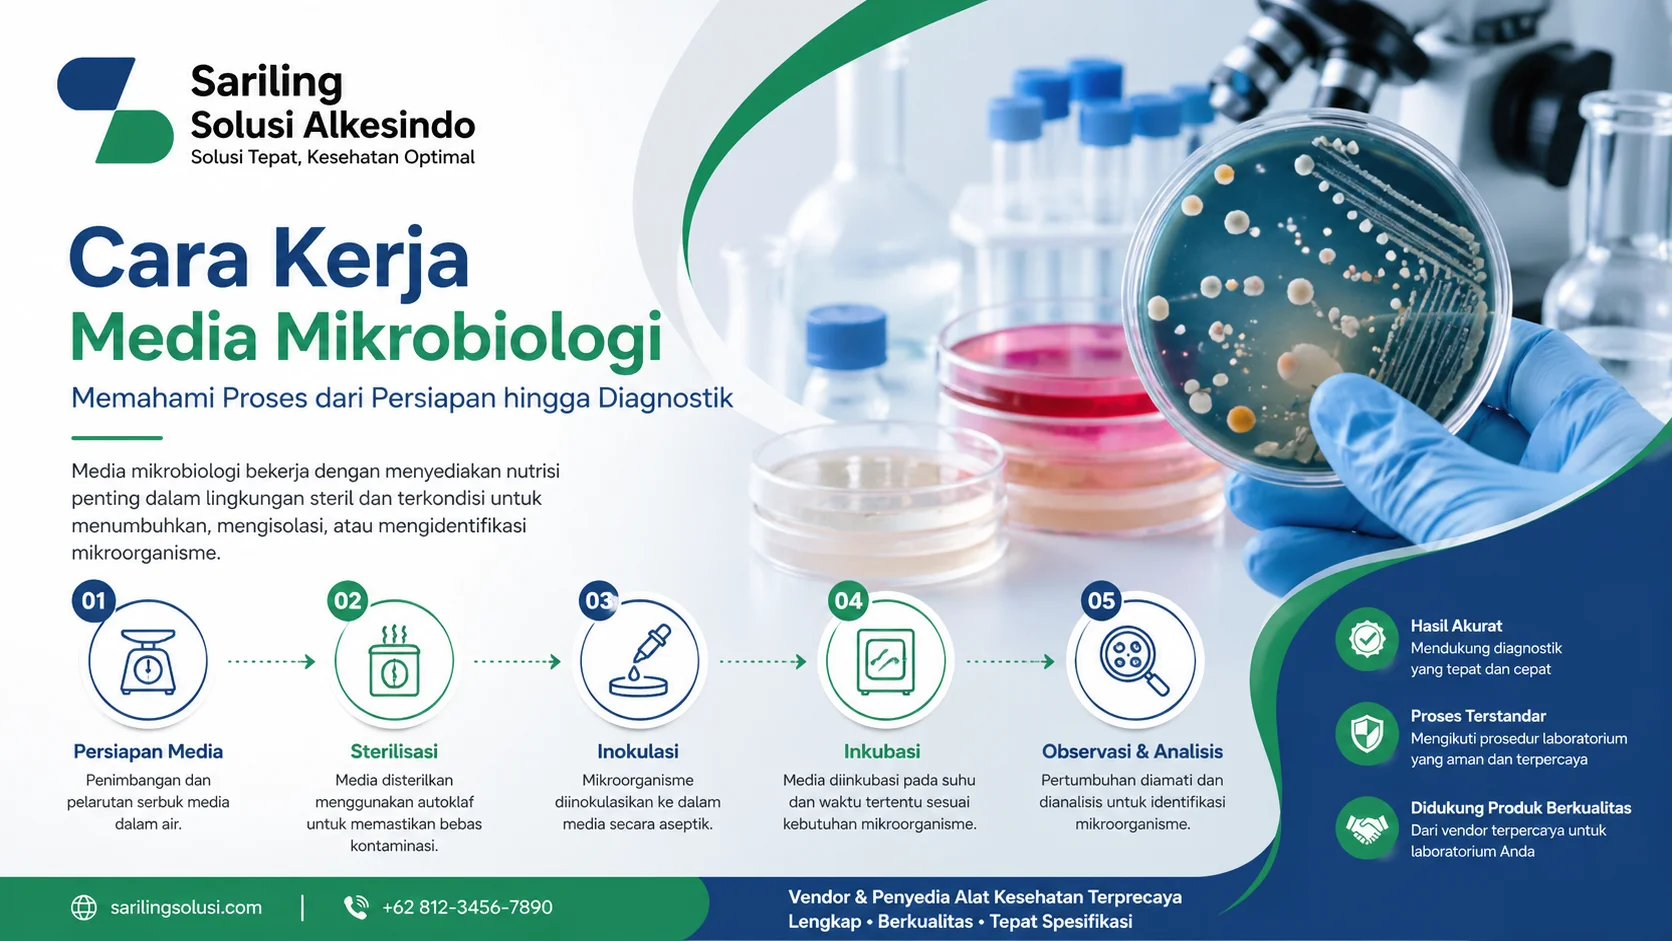
Cara kerja media mikrobiologi di laboratorium mulai dari persiapan, sterilisasi, inokulasi hingga analisis dengan logo Sariling Solusi Alkesindo
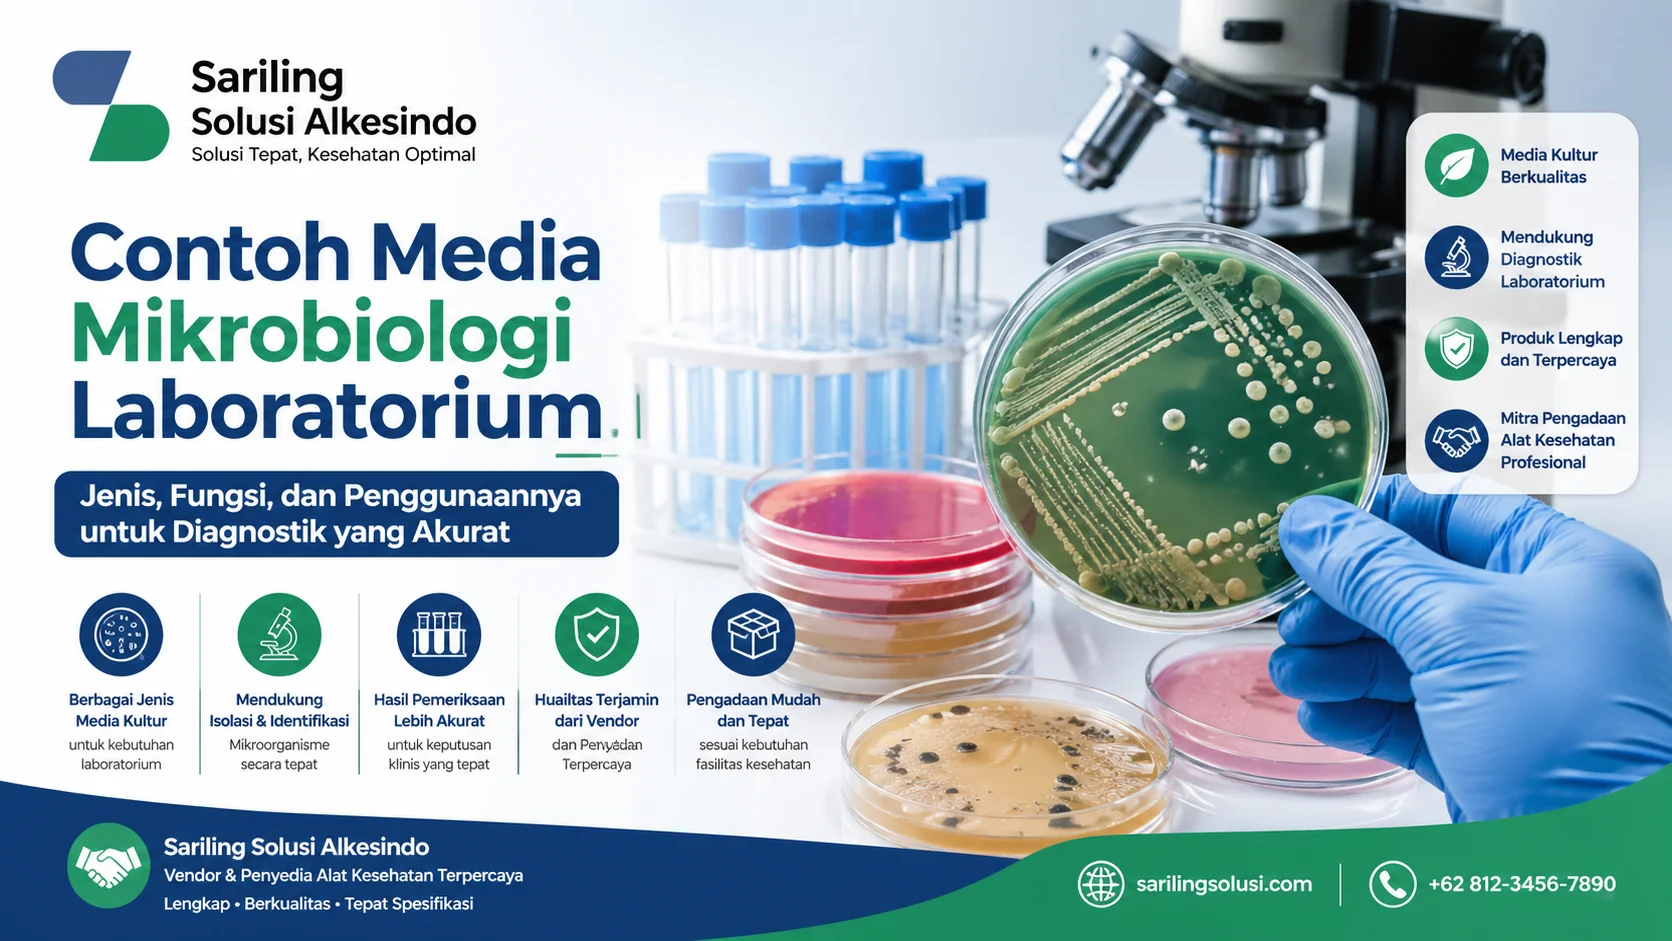
Contoh media mikrobiologi laboratorium seperti petri dish dan tabung uji dengan logo Sariling Solusi Alkesindo untuk diagnostik kesehatan
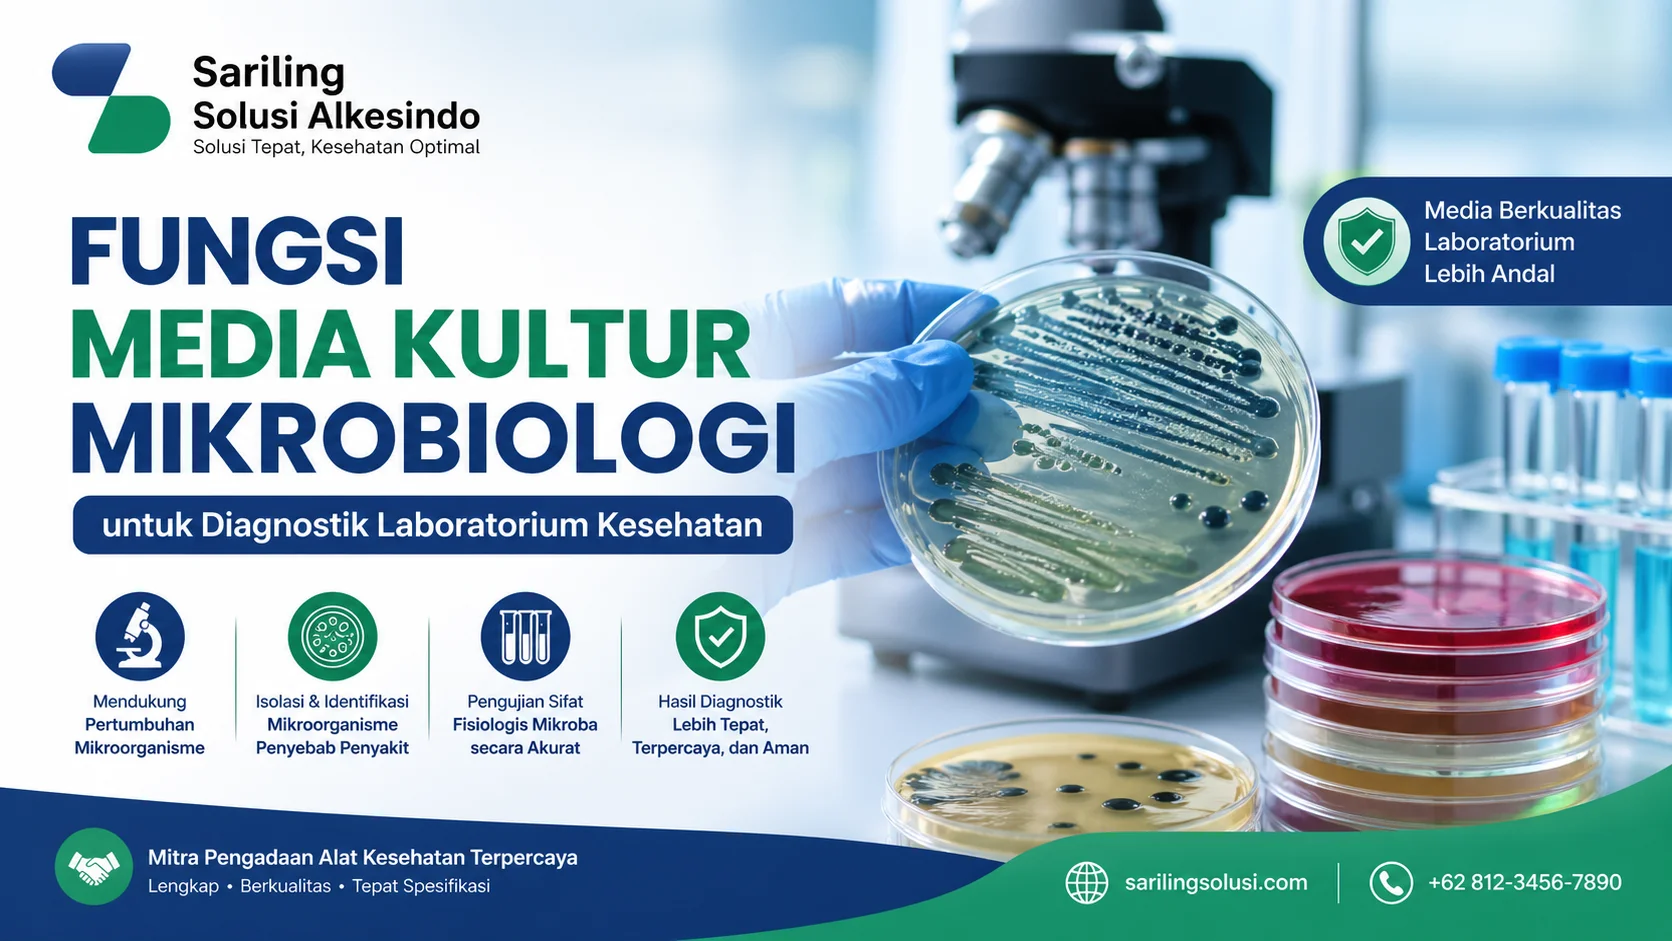
Fungsi media kultur mikrobiologi dalam diagnostik laboratorium dengan ilustrasi petri dish dan logo Sariling Solusi Alkesindo

Pengadaan Test Kit Kesehatan Tepat untuk Instansi Medis
Pengadaan test kit kesehatan adalah proses penyediaan alat diagnostik yang digunakan oleh instansi pemerintah, rumah sakit, dan laboratorium untuk mendeteksi

Pengadaan test kit kesehatan adalah proses penyediaan alat diagnostik yang digunakan oleh instansi pemerintah, rumah sakit, dan laboratorium untuk mendeteksi

Harga test kit kesehatan menjadi informasi penting bagi rumah sakit, klinik, dan distributor dalam menentukan keputusan pengadaan. Test kit kesehatan

Cara memilih test kit kesehatan adalah proses menentukan alat diagnostik yang sesuai untuk kebutuhan pemeriksaan tertentu agar hasil yang diperoleh

Cara menggunakan test kit adalah proses melakukan pemeriksaan kesehatan dengan alat diagnostik sederhana untuk mengetahui kondisi tertentu secara cepat dan

Jenis test kit kesehatan merupakan berbagai alat diagnostik yang digunakan untuk melakukan pemeriksaan atau skrining kondisi kesehatan secara cepat dan

Manfaat test kit kesehatan adalah memberikan solusi pemeriksaan yang cepat, praktis, dan cukup akurat dalam mendeteksi berbagai kondisi kesehatan. Alat

Contoh gelas volumetric merupakan bagian penting dari alat lab kesehatan yang digunakan untuk mengukur volume cairan secara akurat di laboratorium.

Cara pakai gelas volumetric merupakan hal penting dalam kegiatan laboratorium yang berkaitan dengan pengukuran cairan secara akurat. Alat ini digunakan

Fungsi gelas volumetric sangat penting dalam kegiatan alat laboratorium, khususnya untuk pengukuran volume cairan dengan tingkat akurasi tinggi. Alat ini

Jenis gelas volumetric merupakan bagian penting dari alat ukur laboratorium yang digunakan untuk mengukur volume cairan dengan tingkat akurasi tinggi.

Gelas volumetric laboratorium adalah alat penting dalam kegiatan alat laboratorium yang digunakan untuk mengukur volume cairan secara presisi tinggi. Alat
Dalam operasional laboratorium kesehatan, kualitas hasil pemeriksaan sangat dipengaruhi oleh bahan yang digunakan, salah satunya adalah media mikrobiologi. Oleh karena
Dalam dunia pelayanan kesehatan, ketepatan diagnosis menjadi kunci utama dalam menentukan terapi yang efektif. Salah satu komponen penting yang sering
Dalam dunia laboratorium kesehatan, pemahaman mengenai cara kerja media mikrobiologi menjadi hal yang sangat penting, terutama bagi ASN dan tenaga
Dalam operasional laboratorium kesehatan, pemilihan media yang tepat menjadi faktor penting dalam menunjang hasil diagnostik yang akurat. Salah satu hal
Dalam dunia laboratorium kesehatan, akurasi diagnosis menjadi faktor utama dalam menentukan penanganan pasien. Salah satu elemen penting yang mendukung proses
Perusahaan distributor alat kesehatan terkemuka di Indonesia yang berkomitmen menyediakan produk berkualitas tinggi dengan standar internasional.
© 2024 Powered by Sariling Solusi Alkesindo